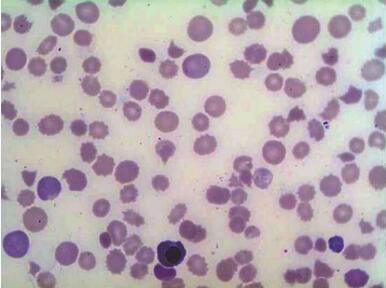
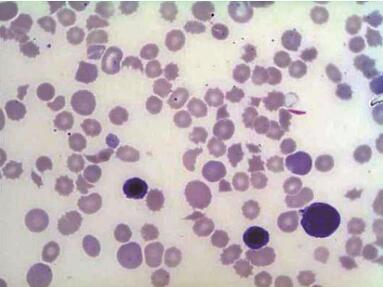

老奶奶发热、全身乏力后皮肤出现瘀斑 几经周转才查明病因
74岁女性,7天前无明显诱因下发热,全身乏力,就诊当地医院被诊断为“急性上呼吸道感染”,出现四肢皮肤瘀斑,当地医院行血常规检查:PLT 2×109/L,住院治疗后出现反复意识不清转上级医院,拟“血小板减少待查”收入急诊监护室。该患者最终被诊断为……
【简要病史】
患者,女,74岁,7天前无明显诱因下发热,全身乏力,无咳嗽咳痰,无胸闷气喘,无恶心呕吐,无牙龈及鼻出血,无血尿黑便,就诊当地医院诊断为“急性上呼吸道感染”,并出现四肢皮肤瘀斑,就诊当地医院行血常规检查:PLT 2×109/L,住院治疗后出现反复意识不清转上级医院,拟“血小板减少待查”收入急诊监护室。
【相关检查】
血常规:WBC 15.14×109/L,Hb 80g/L,PLT 9×1012/L,RET 16.0%。生化检查:TP 60.9g/L,TBIL 45μmol/L,DBIL 17μmol/L,IBIL 28μmol/L,TG 1.95mmol/L,BUN 11.3mmol/L;Na146mmol/L,LDH 847IU/L,Ca1.97mmol/L,P 0.86mmol/L。心肌酶谱检查:LDH 1565IU/L,AST 61IU/L,a-HBDH 1371IU/L。凝血检查:纤维蛋白原1.6g/L,D-二聚体5390μg/L。
【典型图片】
外周血图片
图1 异形红细胞,×1000
图2 多种异形红细胞易见,×1000
【讨论】
甲:看到很多破碎红细胞,胆红素也升高,网织红细胞升高,有溶血现象,考虑TTP。
乙:患者有发热,出血,意识障碍,外周血有较多破碎RBC,提示微血管性溶血性贫血,TTP可能。
【分析】
血栓性血小板减少性紫癜(thrombotic thrombocytopenic purpura,TTP)是一种严重的弥散性血栓性微血管病,以微血管病性溶血性贫血、血小板聚集消耗性减少,以及微血栓形成造成器官损害(如肾脏、中枢神经系统等)为特征。TTP预后差,病程短,不及时治疗病死率80%~90%,随着血浆置换的临床应用,预后大大改观,病死率降至10%~20%。近年来继发于其他疾病和药物的TTP患者增多,发病率呈上升趋势,发病以女性稍多,且好发于育龄期,随着对该病认识进一步深入,诊断率不断提高。
TTP的诊断依据主要有:①血小板减少且寿命缩短;②正细胞正色素性贫血、血片中可见较多的畸形红细胞(>2%)与红细胞碎片,网织红细胞计数升高、血胆红素升高(黄疸,以IBIL为主)、乳酸脱氢酶升高等微血管病性溶血性贫血等证据;③神经精神异常;④肾脏损害;⑤发热。上述5方面合称为TTP五联征。此外ADAMTS13测定、凝血象检查、直接Coombs试验、组织病理学检查等辅助检查也具有较高的诊断和鉴别诊断价值。
临床上,TTP的诊断一般不难,但要注意与溶血性尿毒症综合征(hemolytic uremia syndrome,HUS)、弥漫性血管内凝血(disseminated intravascular coagulation,DIC)、Evans综合征等相似疾病进行鉴别诊断。
【诊断】
典型血栓性血小板减少性紫癜(TTP)。
作者:徐卫益 审核:张士化
(环球医学编辑:余霞霞)
来源:《特殊血液病分析100例》
作者:吴茅 王福斌 林慧君 冯晓
页码:76-77
出版:人民卫生出版社
- 评价此内容
- 我要打分
近期推荐
热门关键词
最新会议
- 2013循证医学和实效研究方法学研讨会
- 欧洲心脏病学会年会
- 世界帕金森病和相关疾病2013年会议
- 英国介入放射学学会2013年第25届年会
- 美国血液学会2013年年会
- 美国癫痫学会2013年第67届年会
- 肥胖学会 2013年年会
- 2013年第9届欧洲抗体会议
- 国际精神病学协会 2013年会议
- 妇科肿瘤2013年第18届大会
- 国际创伤压力研究学会2013年第29届…
- 2013年第4届亚太地区骨质疏松症会议
- 皮肤病协会国际2013年会议
- 世界糖尿病2013年大会
- 2013年国际成瘾性药年会
- 彭晓霞---诊断试验的Meta分析
- 武姗姗---累积Meta分析和TSA分析
- 孙凤---Network Meta分析
- 杨智荣---Cochrane综述实战经验分享
- 杨祖耀---疾病频率资料的Meta分析
合作伙伴
Copyright g-medon.com All Rights Reserved 环球医学资讯 未经授权请勿转载!
网络实名:环球医学:京ICP备08004413号-2
关于我们|
我们的服务|版权及责任声明|联系我们
互联网药品信息服务资格证书(京)-经营性-2017-0027
互联网医疗保健信息服务复核同意书 京卫计网审[2015]第0344号




会员登录

